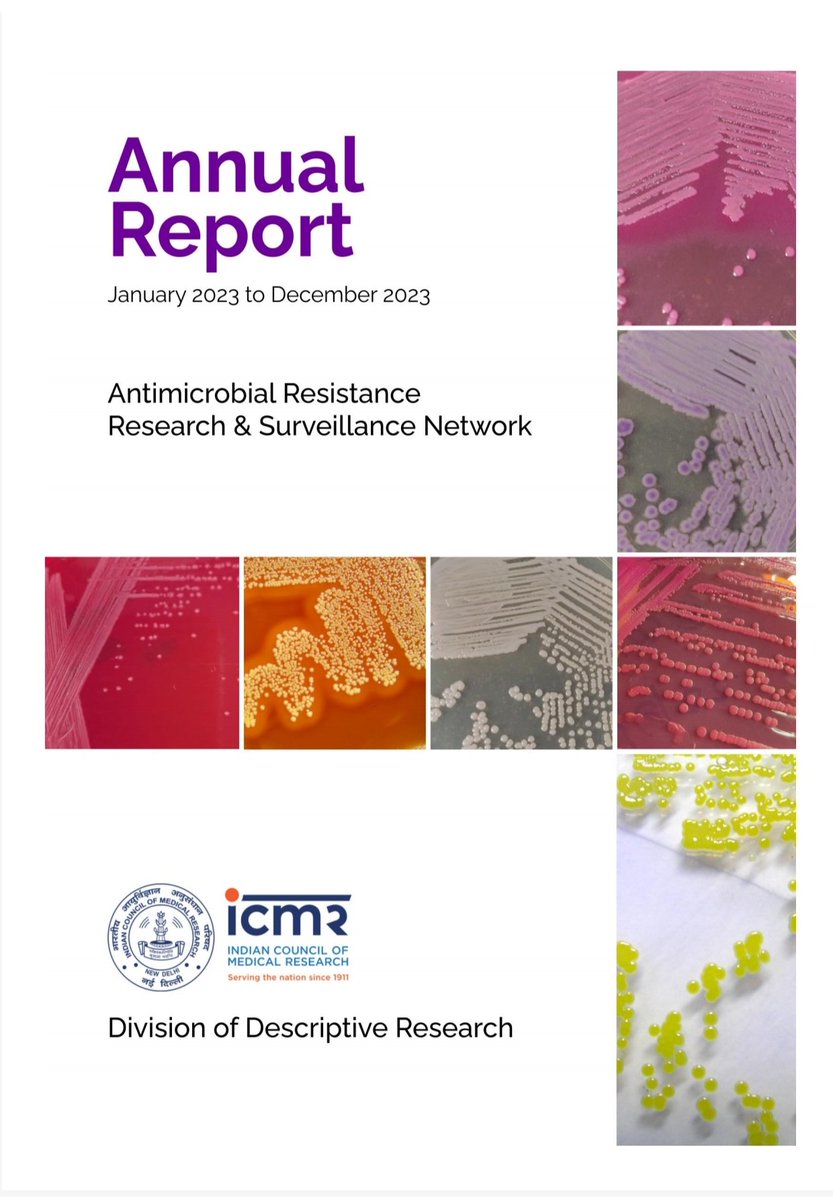
<a href="/ICMRDELHI/">ICMR</a> #AMR surveillance network report for the year 2023 is now available at
main.icmr.nic.in/sites/default/…
#antimicrobialresistance
<a href="/NCDCMoHFW/">National Centre for Disease Control</a> <a href="/MoHFW_INDIA/">Ministry of Health</a>

Sonam Vijay 🇮🇳
@sonamvijay26
Indian Council of Medical Research(ICMR)
Focus on Antimicrobial resistance; Antimicrobial Stewardship; National Essential Diagnostics List; Malaria
ID: 857452951433994240
27-04-2017 04:34:49
201 Tweet
56 Followers
98 Following

ICMR #AMR surveillance network report for the year 2023 is now available at main.icmr.nic.in/sites/default/… #antimicrobialresistance National Centre for Disease Control Ministry of Health

Smt. Anupriya Patel, Minister of State, Ministry of Health & Family Welfare, delivered India’s intervention at the United Nations General Assembly High-Level Meeting on #AMR. She highlighted India’s progress under the National Action Plan since 2017 and the strengthened

Excellent speech by MoS Anupriya Patel #UNGA2024 in recognition of all the work done on #AMR in India by NCDC India ICMR CDSCO_INDIA_INFO FSSAI DBT-BIRAC Indian Council of Agricultural Research. and all the dedicated scientists and researchers. Some milestones achieved but miles to go!!

Happy to be attending #G7 Health Ministers meeting at Ancona, Italy #AMR #climatechange ICMR NCDC India Ministry of Health


Chief minister Omar Abdullah releasing the antibiotics policy is a great beginning for #AMR containment efforts in the State. Kudos to #AMS team Sher-i-Kashmir Institute Of Medical Sciences for commitment and splendid work!!


India ( Sonam Vijay 🇮🇳), Nepal (Dr. Kamana Sharma), & an in-depth presentation from India on diagnostics implementation (thanks Dr Yogita). Tomorrow, we continue our work, committed to supporting Thailand in their endeavor of strengthening diagnostics for all. #NEDL #Thailand #WHO





Hon'ble Prof. Vinod Kumar Paul, Member NITI Aayog, launched the Expansion of ICMR Antimicrobial Resistance Surveillance & Research Network (AMRSN) to secondary-level hospitals. This initiative will expand footprint of AMR surveillance beyond tertiary care.


Secretary, Department of Health Research, MoHFW & DG, ICMR emphasized the need for generating high-quality, reliable AST data to guide evidence-based interventions for all levels of health care.


















